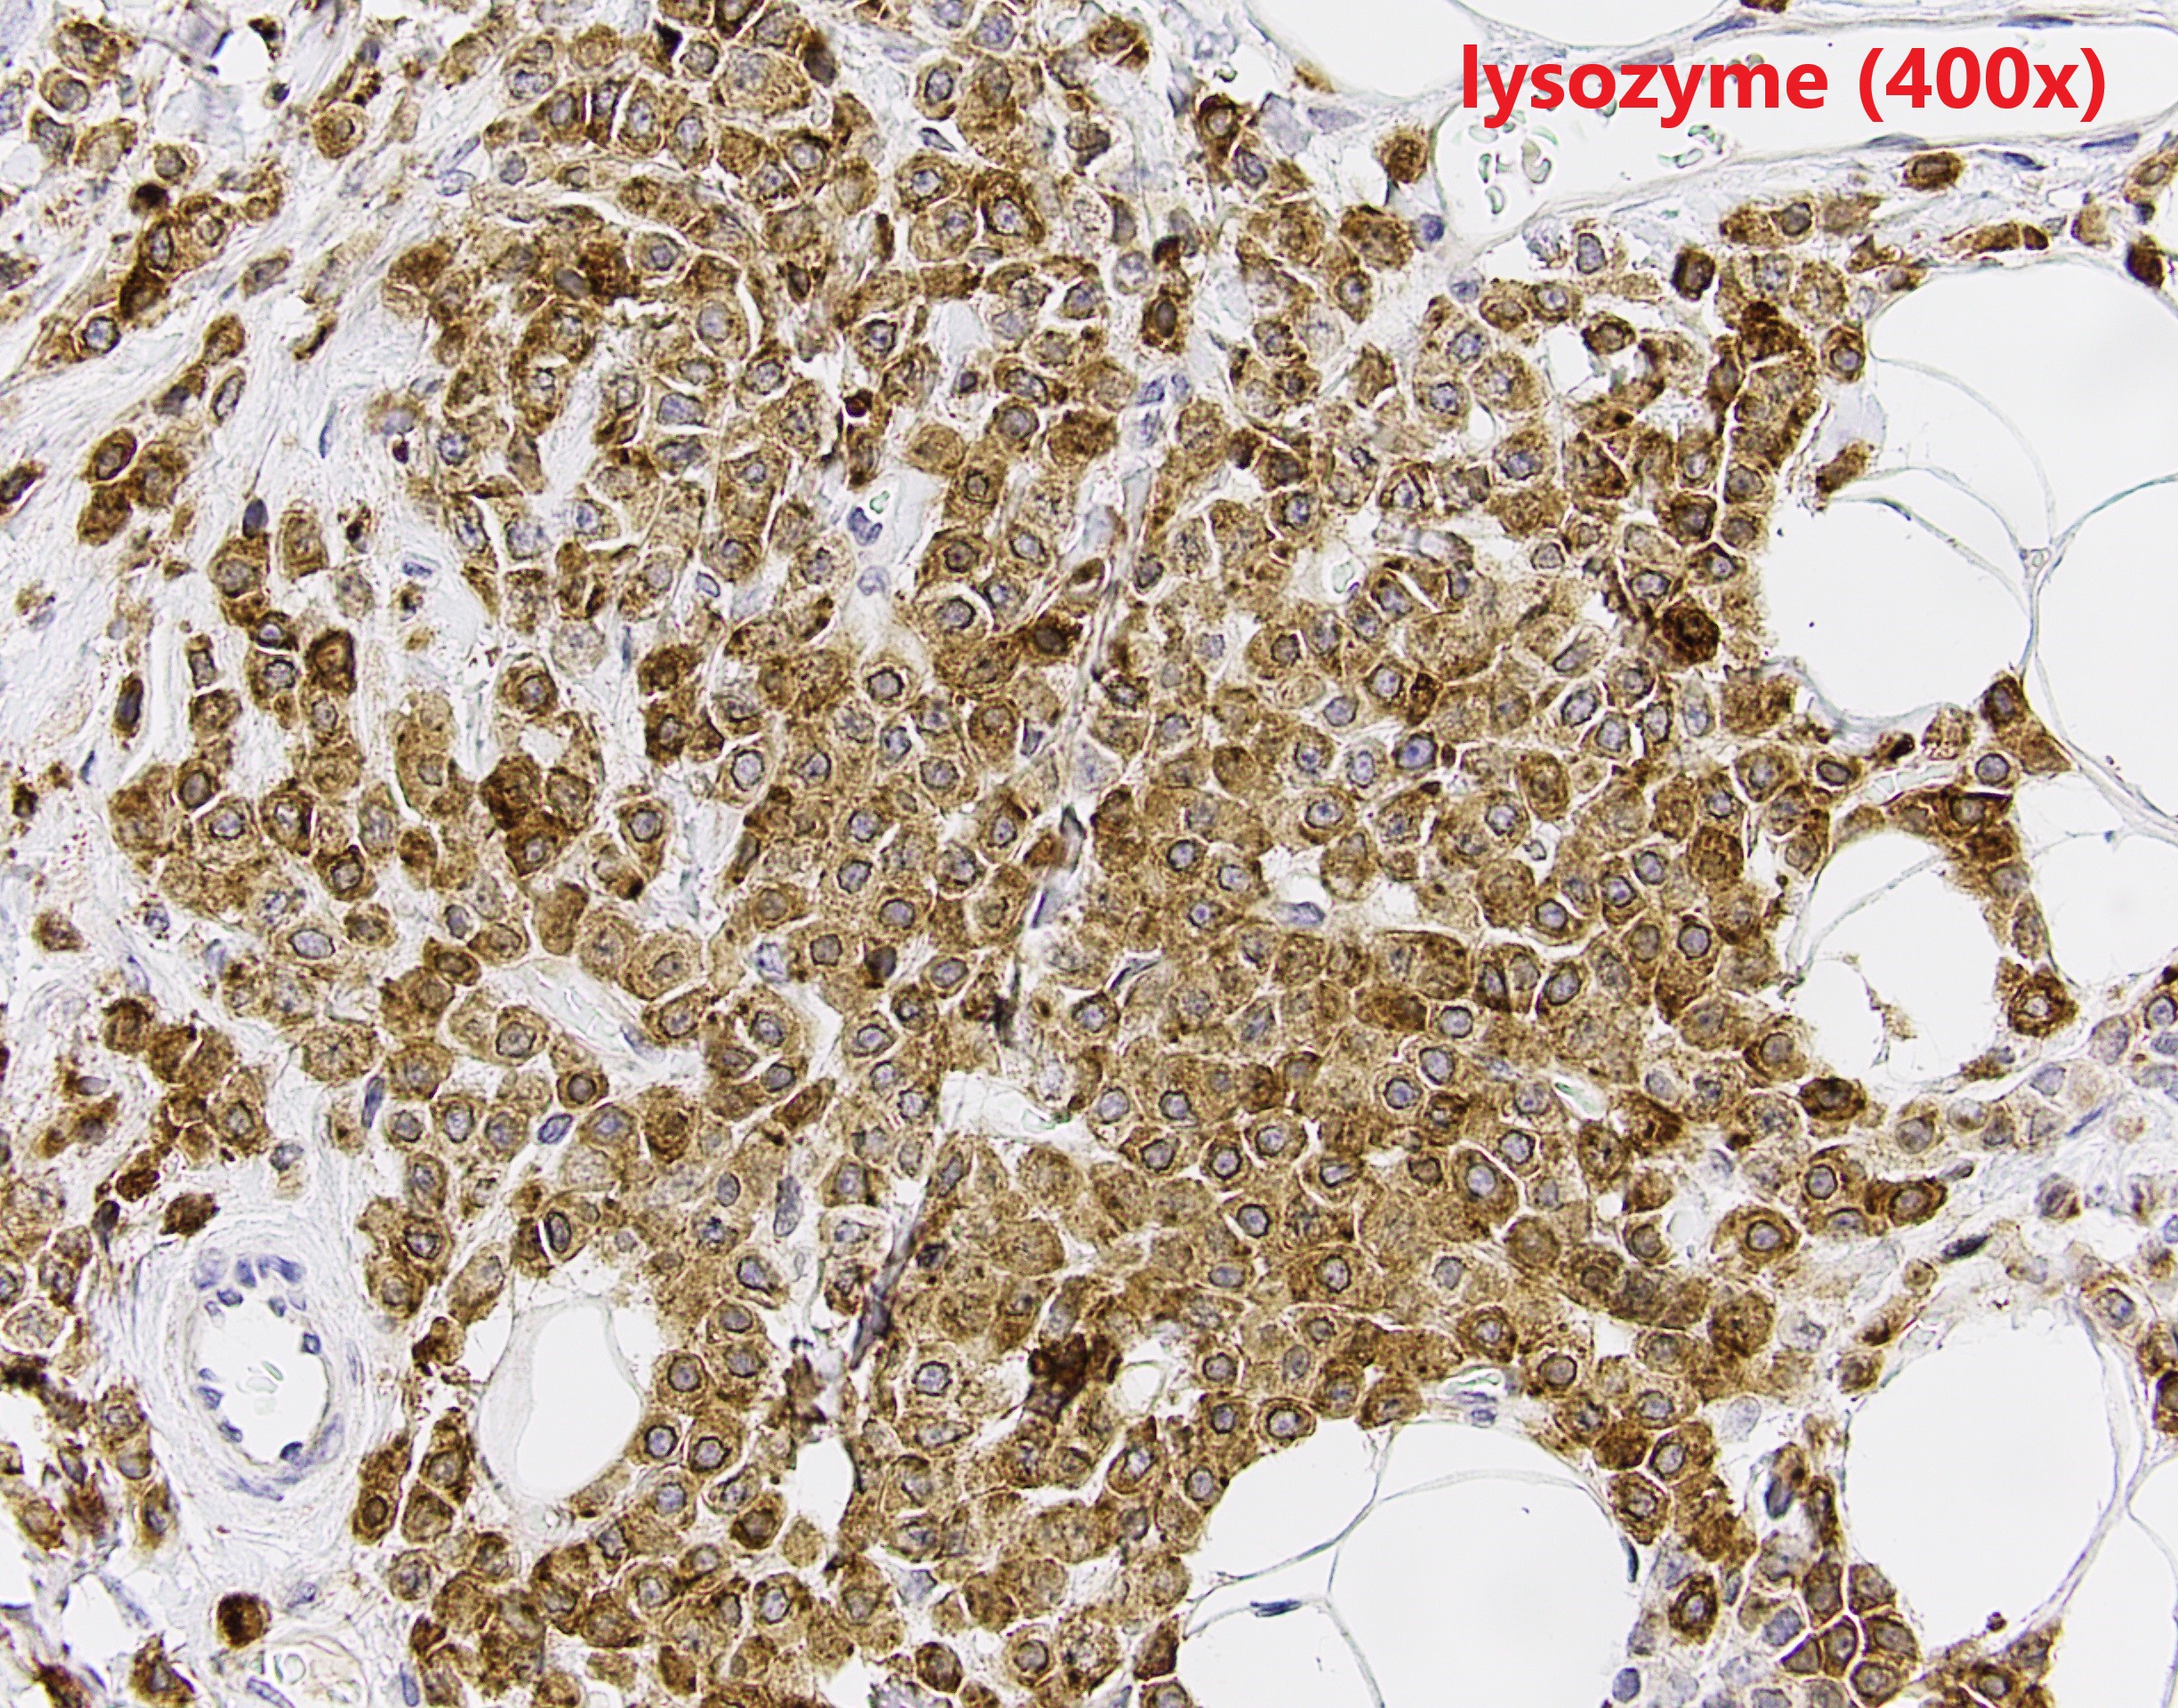

Case History
The patient is a middle-aged female with an irregular enhancing mass in the right breast. After resection, IHC revealed GATA3 and CK7 positivity and p63 negativity. Further studies of lysozyme and a1-antichymotrypsin are shown.
What is the diagnosis?
A. ILC, pleomorphic variant
B. Adenomyoepithelioma
C. Lobular cancerization
D. Acinic cell carcinoma

Answer: D. Acinic Cell Carcinoma
Discussion:
Breast acinic cell carcinoma (ACC) is a rare entity and usually affects women aged 20-80 years. Architectural patterns of ACC are variable, ranging from microglandular proliferation to solid. Diagnosis of ACC is mainly based on cytological features. The tumor cells show abundant eosinophilic to clear cytoplasm with coarse granules. The nuclei are usually centrally located with prominent nucleoli. Cytological atypia and mitosis can be seen. The tumor cells are usually triple negative, and positive for S100, EMA, lysozyme and α1-antichymotrypsin. The differential diagnosis is broad depends on cytomorphology. The prognosis of ACC is still unclear because the limited number of cases reported. Most of the reported patient had chemoradiation and surgery.
Reference: Breast Tumours. WHO Classification of Tumors, 5th Edition